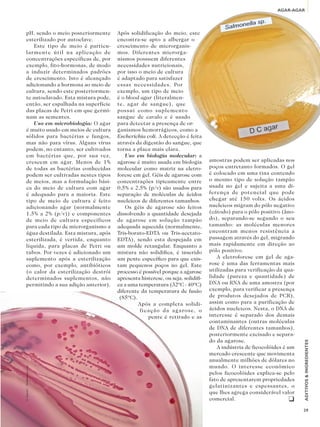
AGAR-AGAR




      pH, sendo o meio posteriormente      Após solidificação do meio, este
      esterilizado por autoclave.          encontra-se apto a albergar o
          Este tipo de meio é particu-     crescimento de microrganis-
      larmente útil na aplicação de        mos. Diferentes microrga-
      concentrações específicas de, por    nismos possuem diferentes
      exemplo, fito-hormonas, de modo      necessidades nutricionais,
      a induzir determinados padrões       por isso o meio de cultura
      de crescimento. Isto é alcançado     é adaptado para satisfazer
      adicionando a hormona ao meio de     essas necessidades. Por
      cultura, sendo este posteriormen-    exemplo, um tipo de meio
      te autoclavado. Esta mistura pode,   é o blood agar (literalmen-
      então, ser espalhada na superfície   te, agar de sangue), que
      das placas de Petri em que germi-    possui como suplemento
      nam as sementes.                     sangue de cavalo e é usado
          Uso em microbiologia: O agar     para detectar a presença de or-
      é muito usado em meios de cultura    ganismos hemorrágicos, como a
      sólidos para bactérias e fungos,     Escherichia coli. A detecção é feita
      mas não para vírus. Alguns vírus     através da digestão do sangue, que
      podem, no entanto, ser cultivados    torna a placa mais clara.
      em bactérias que, por sua vez,          Uso em biologia molecular: a
      crescem em agar. Menos de 1%         agarose é muito usada em biologia         amostras podem ser aplicadas nos
      de todas as bactérias conhecidas     molecular como matriz na eletro-          poços entretanto formados. O gel
      podem ser cultivadas nestes tipos    forese em gel. Géis de agarose com        é colocado em uma tina contendo
      de meios, mas a formulação bási-     concentrações tipicamente entre           o mesmo tipo de solução tampão
      ca do meio de cultura com agar       0,5% e 2,5% (p/v) são usados para         usada no gel e sujeita a uma di-
      é adequado para a maioria. Este      separação de moléculas de ácidos          ferença de potencial que pode
      tipo de meio de cultura é feito      nucleicos de diferentes tamanhos.         chegar até 150 volts. Os ácidos
      adicionando agar (normalmente           Os géis de agarose são feitos          nucleicos migram do pólo negativo
      1,5% a 2% (p/v)) e componentes       dissolvendo a quantidade desejada         (cátodo) para o pólo positivo (âno-
      de meio de cultura específicos       de agarose em solução tampão              do), separando-se segundo o seu
      para cada tipo de microrganismo a    adequada aquecida (normalmente,           tamanho: as moléculas menores
      água destilada. Esta mistura, após   Tris-borato-EDTA ou Tris-acetato-         encontram menos resistência a
      esterilizada, é vertida, enquanto    EDTA), sendo esta despejada em            passagem através do gel, migrando
      líquida, para placas de Petri ou     um molde retangular. Enquanto a           mais rapidamente em direção ao
      tubos. Por vezes é adicionado um     mistura não solidifica, é inserido        pólo positivo.
      suplemento após a esterilização      um pente específico para que exis-           A eletroforese em gel de aga-
      como, por exemplo, antibióticos      tam pequenos poços no gel. Este           rose é uma das ferramentas mais
      (o calor da esterilização destrói    processo é possível porque a agarose      utilizadas para verificação da qua-
      determinados suplementos, não        apresenta histerese, ou seja, solidifi-   lidade (pureza e quantidade) de
      permitindo a sua adição anterior).   ca a uma temperatura (32ºC - 40ºC)        DNA ou RNA de uma amostra (por
                                           diferente da temperatura de fusão         exemplo, para verificar a presença
                                            (85ºC).                                  de produtos desejados de PCR),
                                                    Após a completa solidi-          assim como para a purificação de
                                                    ficação da agarose, o            ácidos nucleicos. Nesta, o DNA de
                                                        pente é retirado e as        interesse é separado dos demais
                                                                                     contaminantes (outras moléculas
                                                                                     de DNA de diferentes tamanhos),
                                                                                     posteriormente excisado e separa-
                                                                                     do da agarose.
                                                                                                                           ADITIVOS & INGREDIENTES




                                                                                        A indústria de ficocolóides é um
                                                                                     mercado crescente que movimenta
                                                                                     anualmente milhões de dólares no
                                                                                     mundo. O interesse econômico
© Jarrod1 - Dreamstime.com




                                                                                     pelos ficocolóides explica-se pelo
                                                                                     fato de apresentarem propriedades
                                                                                     gelatinizantes e espessantes, o
                                                                                     que lhes agrega considerável valor
                                                                                     comercial.                        q

                                                                                                                           39

O documento descreve a história e as propriedades do agar-agar, um hidrocolóide extraído de algas marinhas utilizado como gelificante na indústria alimentícia. O agar-agar é obtido de espécies de algas vermelhas como a Gracilária e tem sido usado desde o século XVII no Japão como geléia e meio de cultura bacteriana. Sua estrutura contém as frações agarose e agaropectina.